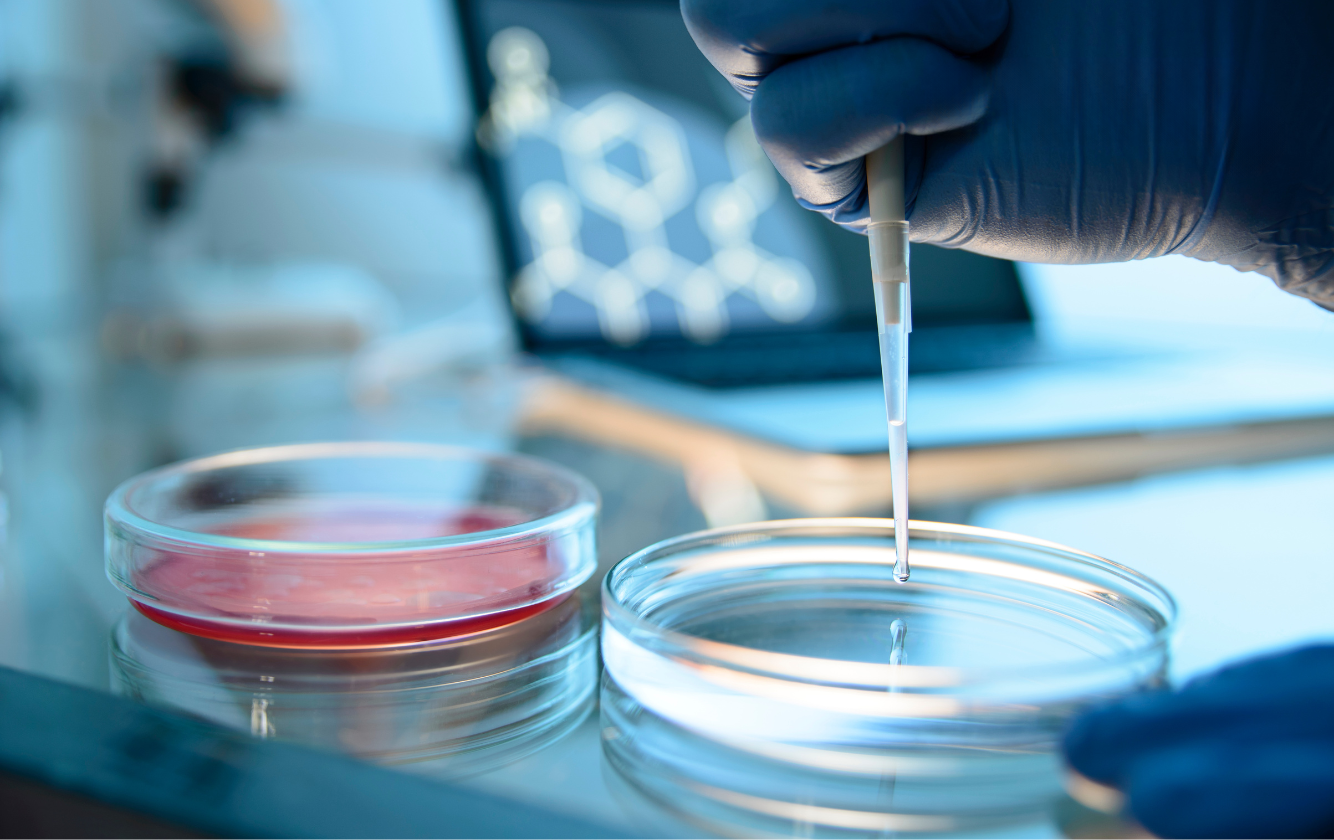
ks-blog3

Non-GLP Bioanalysis
Non-GLP bioanalysis is essential in early-stage drug discovery, measuring drug concentrations in biological matrices during preclinical studies. It delivers rapid DMPK data to support candidate screening, dose selection, and early decision-making—helping advance compounds toward GLP-compliant studies for regulatory submission. WuXi AppTec provides high-quality customized non-GLP bioanalysis services for large molecule drugs, small molecule drugs, biomarkers, immunogenicity, and cell-based assays.
Small Molecules Tested by WuXi AppTec Lab Testing Division
Biological Matrices & Micro Sample Bioanalysis
In Vivo Studies per Year
In Vitro Studies per Year
Non-GLP Bioanalysis Capabilities
WuXi AppTec offers high-efficiency and high-quality non-GLP bioanalytical services to support early-stage drug discovery and development.
With an experienced professional analysis team, advanced analytical instruments, whole-process electronic management, and reliable quality control systems, our work meets the highest standards, allowing drug developers to move faster in discovery and early development.
Multiple Molecular Types
-
- Small molecules: Fatty acids, chiral compounds, macrolides, metal-containing compounds, PROTACs, siRNAs, ASOs.
- Macromolecule biopharmaceuticals: peptides, proteins, antibodies, glycans, ADCs, AOCs, nucleic acids.
- Drug carriers: AAVs, LNPs, liposomes, polymers, DNA nanostructures.
- Biomarkers: amino acids and neurotransmitters, bile acids, vitamins, hormones, glucose metabolism, lipids, tricarboxylic acid cycle
100+ Biological Matrices and Micro Sample Bioanalysis
-
- Various conventional soft and hard tissues.
- Cerebrospinal fluid, microdialysis, PBMC, ophthalmic tissue, etc.
Comprehensive Non-GLP Bioanalytical Assays
and Testing Services
- Immunogenicity Testing – Detects anti-drug antibodies (ADA) and neutralizing antibodies to assess immune response to biologic drugs.
- Pharmacokinetics – Studies how a drug moves through the body (absorption, distribution, metabolism, and excretion).
- Biomarker Analysis – Measures single or multiple biomarkers to track disease states, drug effects, and safety.
- Receptor Binding & Occupancy – Evaluates how well a drug binds to its target receptor, helping assess efficacy.
- Molecular & Cellular Assays – Includes qPCR, Hybridization ELISA, and Enzyme Activity assays to analyze gene expression and enzyme function.
-
- Immunophenotyping – Identifies immune cell types and markers, including intracellular and nuclear markers.
- PBMC & RNA Sample Prep – Prepares immune cells and RNA for further analysis.
- In Vitro Stimulation Assays – Tests immune responses to different stimuli.
- Biodistribution Studies – Tracks how a drug spreads through the body over time.
- Immune & Inflammation Panels – Measures immune response, inflammation markers, and heart damage indicators (Th1/Th2 cytokines, chemokines, TDAR, and myocardial damage markers).
Non-GLP Bioanalysis for Small Molecule Drugs
WuXi AppTec offers high-quality non-GLP bioanalytical services to support early development of small molecule drugs. Leveraging LC-MS, HPLC, UPLC, and hybrid LBA-LC-MS platforms, we deliver rapid, reliable data to accelerate screening, DMPK assessment, and informed decision-making.
Small Molecule Bioanalytical Instrumentation
WuXi AppTec’s bioanalytical instrument platform supports high-throughput bioanalysis. We were the first company in China to apply Apricot Designs Dual Arm and MPXTM-2/Shimadzu Nexera UHPLC-30A LC-MS/MS.
Liquid Chromatography Platforms
We leverage industry-leading UPLC™, UHPLC, and high-throughput autosamplers to enhance bioanalytical efficiency and precision.
- Shimadzu Nexera UHPLC-30A
- Waters ACQUITY™ UPLC™, ACQUITY™ UPLC™ I-Class PLUS, Alliance HPLC
- CTC Analytics Dynamic Load Wash
- Apricot Designs Dual Arm (ADDA Auto Sampler System)
- MPX™-2 Shimadzu Nexera UHPLC-30A
Mass Spectrometry Technologies
Our bioanalysis capabilities are powered by first-class triple quadrupole and high-resolution mass spectrometry systems.
Triple Quadrupole MS Systems
- SCIEX Triple Quad™ 5500+/6500+
- SCIEX QTRAP® 6500
High-Resolution MS Systems
- Thermo Scientific™ Q Exactive™ Plus, Q Exactive™ HF
- Waters Xevo® G2-XS QTof™
Small Molecule Non-GLP Bioanalysis
Biological matrices
Types of experiments
Compounds/year
Non-GLP Bioanalysis for Large Molecule Drugs
WuXi AppTec offers non-GLP bioanalysis for a broad range of biologics, including monoclonal and bispecific antibodies, recombinant and fusion proteins, biosimilars, peptides, antibody drug conjugates (ADCs), PEGylated biologics, hormones, oligonucleotides, gene therapy products and vaccines. We have established and tested methods, along with ready-to-use reagents, for reliable and efficient bioanalysis.
Large Molecule Bioanalytical Instrumentation
- Flow Cytometry: BD FACSCanto™ II, BD LSRFortessa™ Flow Cytometer
- Plate Readers & Detection: SpectraMax® M2e/M5 with SoftMax® Pro GxP 5.4.1 (or equivalent), MESO™ QuickPlex SQ 120 system
- Automation & Sample Processing: Tecan EVO® Automated ELISA Workstation, Hamilton Microlab® Star™ Workstation, Bio-Tek® Plate Washer
- PCR & Molecular Analysis: QuantStudio™ 7 Flex Real-Time PCR System, PCR Thermal Cycler
- Data Integration: Watson LIMS™ (seamless link to plate readers)
Large Molecule Non-GLP Bioanalysis
Bioanalytical platforms
Methods/year
Biological matrices
Explore PK/ADME Insights
Non-GLP Bioanalysis FAQ
What is non-GLP Bioanalysis?
Non-GLP bioanalysis refers to the generation of high-quality bioanalytical data under non-regulated conditions to support early-stage drug development. For drug developers, it provides a flexible, efficient approach to assess pharmacokinetics, metabolism, and preliminary safety before entering formal GLP studies. By enabling rapid candidate screening, dose selection, and data-driven decision-making, non-GLP bioanalysis helps accelerate development timelines and reduce early-phase risk.
What’s the difference between non-GLP and GLP bioanalysis?
Non-GLP bioanalysis is used in early-stage research for method development, screening, and exploratory studies, prioritizing speed and flexibility. This is because non-GLP studies don’t require the same level of documentation as GLP studies. GLP bioanalysis follows strict regulatory guidelines to ensure data integrity and compliance for regulatory submissions, making it essential for later-stage studies like preclinical and clinical trials.
However, whether GLP or non-GLP, you should always have qualified personnel handling your samples, calibrated instruments, and clean, well-organized, and temperature-controlled facilities.
How does non-GLP bioanalysis fit into DMPK testing?
Non-GLP bioanalysis plays a vital role in DMPK testing by providing rapid, flexible data to support early drug discovery. It enables efficient assessment of pharmacokinetics, metabolism, and preliminary safety, helping drug developers accelerate candidate screening, optimize dose selection, and make faster, data-driven decisions to advance their programs.